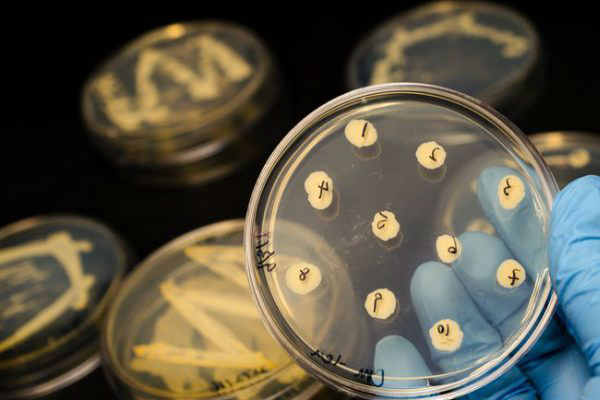

Naučnici su zabrinuti zbog bakterije koja jede meso i koja bi mogla biti prisutna u svakoj američkoj državi na istočnoj obali u narednih 20 godina.
Do 2040-ih, godišnji slučajevi Vibrio vulnificusa mogli bi se udvostručiti kao rezultat zagrevanja okeana uzrokovanog klimatskim promenama, prema istraživačima sa Univerziteta Istočne Anglije u Velikoj Britaniji, prenosi Dejli Mejl.
Kažu da klimatske promene omogućavaju bakteriji da preživi u vodama severnije nego ikada, dok bi porast nivoa mora mogao da gurne bakterije dalje u unutrašnjost.Centar za kontrolu i prevenciju bolesti procenjuje da je 80.000 Amerikanaca zaraženo vibrionom svake godine, iako postoji samo 1.200 do 2.000 potvrđenih slučajeva godišnje jer se često pogrešno dijagnostikuje.
Toksične bakterije razvijaju se u toploj, slanoj i plitkoj vodi duž obale i reaguju na najmanje promene temperature.
Trenutno je najčešći u obalnim vodama Severne Karoline.
Infekcije kod ljudi su retke, ali dostižu vrhunac u letnjim mesecima. Ljudi dobijaju infekcije kroz otvorene posekotine ili druge lezije kože koje dolaze u kontakt sa morskom vodom.
Infekcije se brzo šire kod ljudi i mogu ozbiljno oštetiti ljudsko meso. Ne možete se zaraziti od druge osobe.
Simptomi uključuju vodenu dijareju, često praćenu grčevima u stomaku, mučninom, povraćanjem i temperaturom.
Ostali znaci uključuju zimicu, lezije kože i smrtonosni pad krvnog pritiska.
Neke infekcije dovode do nekrotizirajućeg fasciitisa, teške infekcije u kojoj meso oko rane odumire.
Otprilike jedna od pet osoba sa infekcijom umre, ponekad u roku od dan ili dva nakon što se razboli. Drugi mogu zahtevati intenzivnu negu ili amputacije udova.
Ljudi obično umiru od infekcije kada ona uđe u krvotok i izazove sepsu.
Do infekcije može doći i kada neko konzumira sirovu ili nedovoljno kuvanu ribu.Kako sprečiti razvoj infekcije?
Pošto ne postoje vakcine za sprečavanje infekcija, uključujući nekrotizirajući fasciitis, rane moraju brzo da zarastu kako ne bi prerasle u opasne infekcije. Evo šta možete da urdite kad ase posečete ili povredite, a što će pomoći da sprečite pojavu nekrotizirajućeg fasciitisa,piše Srbijadanas
uvek čistite posekotine i povrede sapunom i vodom;
menjajte u slučaju da često kvasite mesto, moraju da budu suvi;
izbegavajte direktan kontakt vode i povređenog dela.